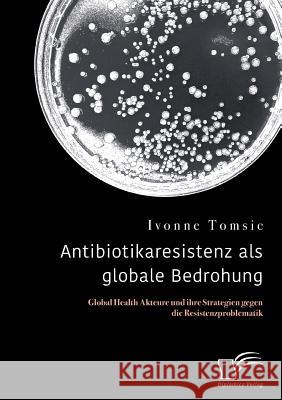
Antibiotikaresistenz als globale Bedrohung. Global Health Akteure und ihre Strategien gegen die Resistenzproblematik Ivonne Tomsic 9783961465934 Diplomica Verlag - książka

Antibiotikaresistenz als globale Bedrohung. Global Health Akteure und ihre Strategien gegen die Resistenzproblematik » książka
topmenu
Antibiotikaresistenz als globale Bedrohung. Global Health Akteure und ihre Strategien gegen die Resistenzproblematik
ISBN-13: 9783961465934 / Niemiecki / Miękka / 2018 / 106 str.
Antibiotikaresistenz als globale Bedrohung. Global Health Akteure und ihre Strategien gegen die Resistenzproblematik
ISBN-13: 9783961465934 / Niemiecki / Miękka / 2018 / 106 str.
cena 236,08
(netto: 224,84 VAT: 5%)
Najniższa cena z 30 dni: 236,08
(netto: 224,84 VAT: 5%)
Najniższa cena z 30 dni: 236,08
Termin realizacji zamówienia:
ok. 16-18 dni roboczych
Bez gwarancji dostawy przed świętami
ok. 16-18 dni roboczych
Bez gwarancji dostawy przed świętami
Darmowa dostawa!